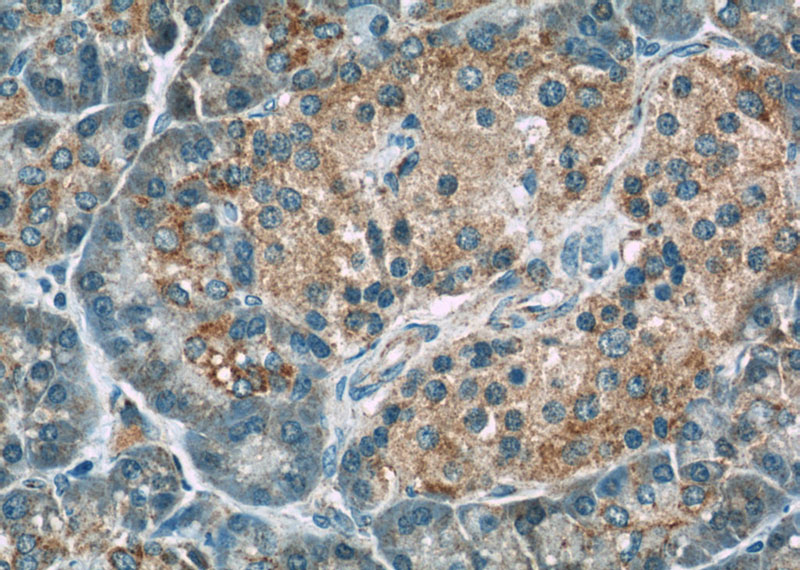
Immunohistochemistry of paraffin-embedded human pancreas slide using Catalog No:113718(PERK Antibody) at dilution of 1:50

-
Product Name
PERK antibody
- Documents
-
Description
PERK Rabbit Polyclonal antibody. Positive WB detected in K-562 cells, HEK-293 cells, MCF7 cells. Positive IHC detected in human pancreas tissue, human placenta tissue. Positive IF detected in HeLa cells. Observed molecular weight by Western-blot: 140 kDa
-
Tested applications
ELISA, WB, IHC, IF
-
Species reactivity
Human; other species not tested.
-
Alternative names
DKFZp781H1925 antibody; EIF2AK3 antibody; HRI antibody; HsPEK antibody; Pancreatic eIF2 alpha kinase antibody; PEK antibody; PERK antibody; WRS antibody
-
Isotype
Rabbit IgG
-
Preparation
This antibody was obtained by immunization of Peptide (Accession Number: NM_004836). Purification method: Antigen affinity purified.
-
Clonality
Polyclonal
-
Formulation
PBS with 0.02% sodium azide and 50% glycerol pH 7.3.
-
Storage instructions
Store at -20℃. DO NOT ALIQUOT
-
Applications
Recommended Dilution:
WB: 1:500-1:5000
IHC: 1:20-1:200
IF: 1:10-1:100
-
Validations

K-562 cells were subjected to SDS PAGE followed by western blot with Catalog No:113718(PERK antibody) at dilution of 1:1000

Immunohistochemistry of paraffin-embedded human pancreas slide using Catalog No:113718(PERK Antibody) at dilution of 1:50
Immunohistochemistry of paraffin-embedded human pancreas slide using Catalog No:113718(PERK Antibody) at dilution of 1:50

Immunofluorescent analysis of HeLa cells using Catalog No:113718(PERK Antibody) at dilution of 1:25 and Alexa Fluor 488-congugated AffiniPure Goat Anti-Rabbit IgG(H+L)
-
Background
PERK, also named as EIF2AK3 and PEK, belongs to the protein kinase superfamily, Ser/Thr protein kinase family and GCN2 subfamily. PERK phosphorylates the alpha subunit of eukaryotic translation-initiation factor 2 (EIF2), leading to its inactivation and thus to a rapid reduction of translational initiation and repression of global protein synthesis. PERK serves as a critical effector of unfolded protein response (UPR)-induced G1 growth arrest due to the loss of cyclin D1. It catalyzes the reaction: ATP + a protein = ADP + a phosphoprotein. Defects in EIF2AK3 are the cause of Wolcott-Rallison syndrome (WRS). The antibody is specific to PERK.
-
References
- Wang ZS, Xiong F, Xie XH, Chen D, Pan JH, Cheng L. Astragaloside IV attenuates proteinuria in streptozotocin-induced diabetic nephropathy via the inhibition of endoplasmic reticulum stress. BMC nephrology. 16:44. 2015.
- Liao H, Bao X, Zhu J. O-Alkylated derivatives of quercetin induce apoptosis of MCF-7 cells via a caspase-independent mitochondrial pathway. Chemico-biological interactions. 242:91-8. 2015.
- Yao Z, Sun B, Hong Q. PACE4 regulates apoptosis in human prostate cancer cells via endoplasmic reticulum stress and mitochondrial signaling pathways. Drug design, development and therapy. 9:5911-23. 2015.
Related Products / Services
Please note: All products are "FOR RESEARCH USE ONLY AND ARE NOT INTENDED FOR DIAGNOSTIC OR THERAPEUTIC USE"
